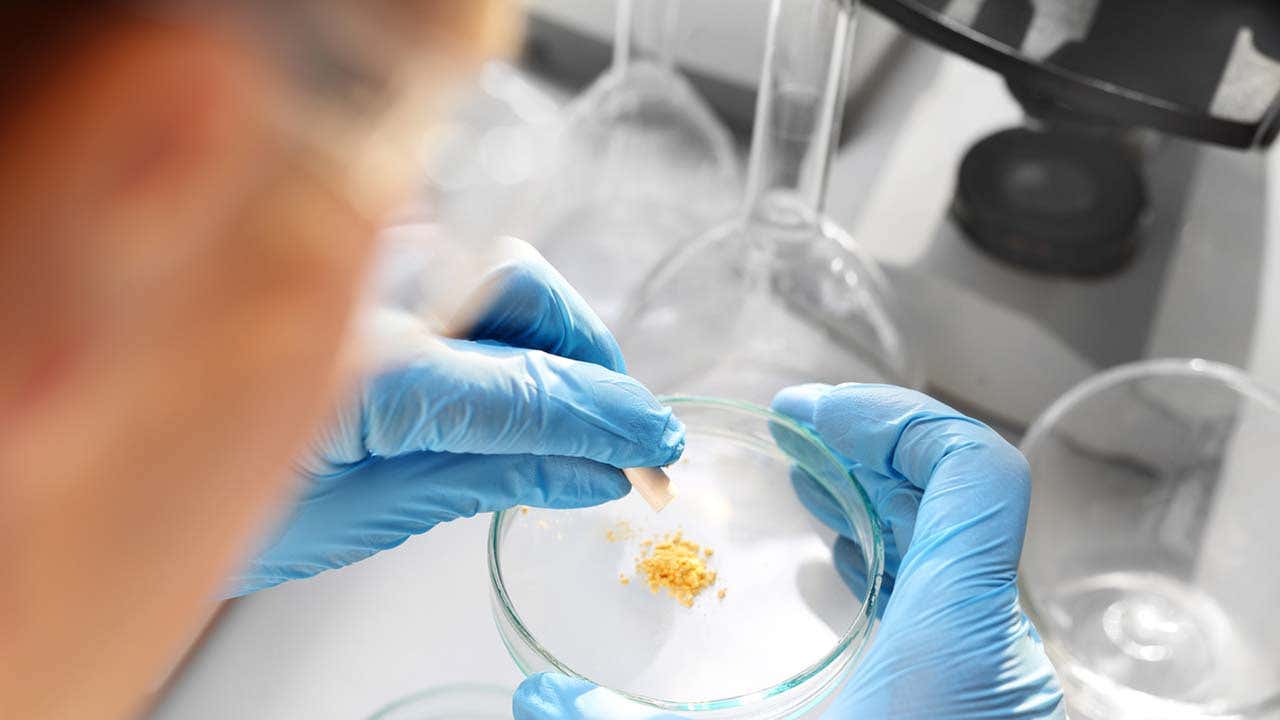

Seleziona l'argomento di tuo interesse e scopri materiali e informazioni utili alla tua professione

Per la gestione quotidiana del tuo paziente affetto da mieloma multiplo
Visita la sezione per leggere gli articoli scritti da colleghi e approfondire tematiche utili alla pratica clinica e non solo